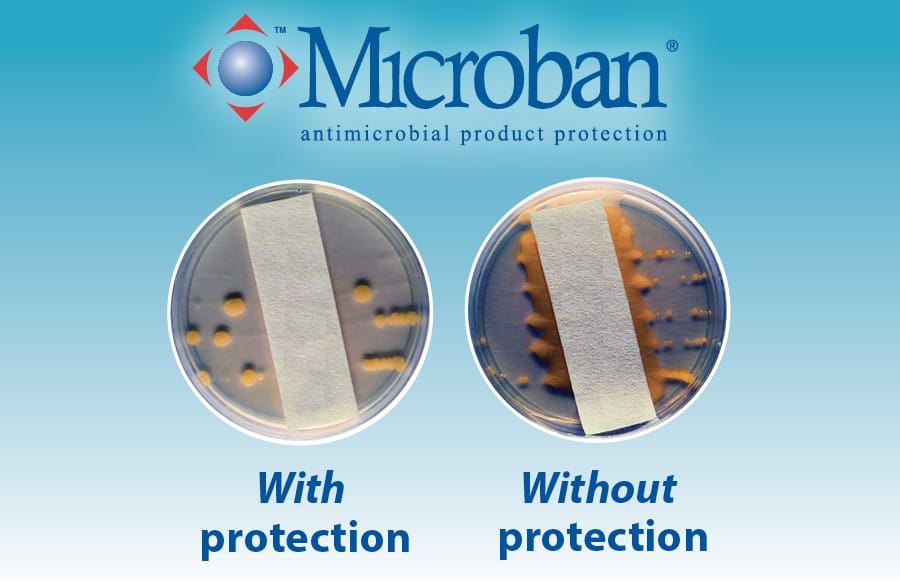
Two petri dishes, one with Microban protection and less microbe growth versus the other dish without Microban.

Pool filtration with maximum results and minimum effort
Our productive, super-sized SmartFilter™ helps keep pool water clean while helping protect the environment, your pocketbook, and your busy schedule.
This national exclusive is also armed with antimicrobial technology. Powerful Microban®* product protection is embedded throughout its cartridge fibers to resist attacks from mold, mildew, and bacteria.
SmartFilter will ensure years of trouble-free operation and crystal-clear water. Blue Haven’s unique filter will:
- Provide up to 6 – 12 months of service before its high-capacity cartridge needs cleaning—depending on filter size, pool use, and backyard conditions;
- Eliminate any need for backwashing—sparing you and Mother Nature the enormous cost of replacing hundreds of gallons of chemically treated water every year;
- Filter water effectively without messy, costly filter powders, or buckets of wet sand;
- Enable cleaning without smelly, often-regulated, DE (diatomaceous earth) to haul off for disposal; and
- Use powerful Microban product protection to fight enemy microbes—so your filter stays fresher for longer.
*MICROBAN is a registered trademark of Microban Products Company.
—Scientifically Proven:
Independent laboratory studies prove that Microban creates a “zone of inhibition” that dramatically impedes growth of microbes that cause stains, odors, and deterioration of filter cartridges.
In addition, unlike surface coatings and chemical additives, Microban will provide enduring, built-in product protection.
Filter tank design benefits




